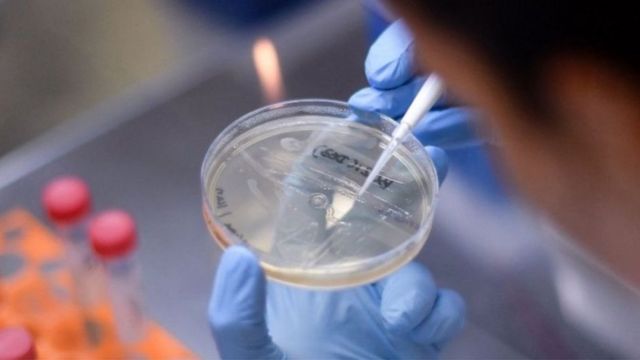

الصحة العالمية تحذر من فيروس كورونا وتطالب باستمرار التطعيم
مدار نيوز/
دعت منظمة الصحة العالمية، صباح اليوم السبت، إلى زيادة تطعيم السكان وإعادة تشجيع ارتداء الكمامات في الأماكن العامة لحماية الناس خلال فصلي الخريف والشتاء من فيروس أوميكون.
وأصدرت منظمة الصحة العالمية بيانا جاء فيه: “يختلف الوضع الوبائي من بلد إلى آخر، وكجزء من الاستعدادات لفصلي الشتاء والخريف، تدعو منظمة الصحة العالمية البلدان إلى استئناف الجهود للتخفيف من تأثير انتشار العدوى والاستعداد للاستجابة للضغط المتزايد على صحتهم”.
وأضافت الوكالة في بيانها: “من الأمور الحاسمة لحماية الأشخاص في فصلي الخريف والشتاء زيادة عدد الأشخاص الذين تم تطعيمهم وإعطاء جرعة معززة ثانية للأفراد الذين يعانون من نقص المناعة الذين تتراوح أعمارهم بين 5 سنوات وما فوق والذين هم على اتصال وثيق بهم”.
وتابع البيان: “كما ندعو لتقديم جرعة معززة ثانية لمجموعات محددة”.
يشار إلى أن “أوميكرون” يسبب أعراضا أقل خطورة، إذ يقل عدد الوفيات الناجمة عن الإصابة به على مستوى العالم مقارنة بالسلالات السابقة من فيروس كورونا.
وحاول العلماء معرفة ما إذا كان السبب في ذلك ارتفاع معدلات المناعة الناتجة عن التطعيم أو الإصابة السابقة بالفيروس أو نتيجة ضعف المتحور الجديد، وانتهت الدراسات إلى أن انخفاض مخاطر الإصابة بأعراض شديدة يُعزى إلى خصائص متحور “أوميكرون” نفسه.
رابط قصير:
https://madar.news/?p=251518





